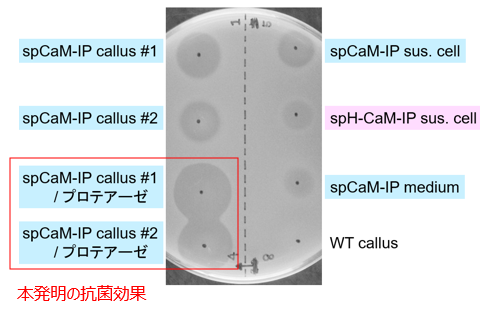
抗菌ぺプチドの生産方法

抗菌ぺプチドの生産方法
畜産疾病予防・治療のための抗菌ペプチド Persulcatusinの低コスト生産方法
概要
畜産業における病害対策として使用される抗生物質は、ヒトの疾患治療での使用と同様に薬剤(多剤)耐性菌を発生させる観点からのみならず、卵/生乳/食肉中での残留による食の安全への懸念からも多用が回避される傾向がある。一方、乳牛の乳房炎などの経済的損失が非常に大きい産業動物の疾病に対し、抗生物質を使用しない予防、治療法として有効なものが少ないことが課題となっている。
東北大学大学院農学研究科の伊藤准教授らは、主としてグラム陽性菌への効果が知られる抗菌性ペプチドPersulcatusin (IP)を植物を用いて効率的に生産する手法を開発した。この手法には、宿主植物に負の影響を与えるペプチドを融合タンパク質として生産することによりその影響を抑制し、タンパク質抽出時に自動的にペプチドを遊離させて活性化させることが可能になる工夫が取り入れてある。

植物葉緑体に融合タンパク質CaM-IP、アポプラストにプロテアーゼを蓄積させ、タンパク質を抽出することにより自動的に遊離したIPが生産されるため、分離・精製が容易になる。
性能・特徴:黄色ブドウ球菌に対する抗菌活性
応用例
・植物で抗菌ペプチドPersulcatusinの大量、低コストでの生産
・植物宿主に負の影響を与えるペプチドの生産
・牛乳房炎予防・治療薬の生産
・グラム陽性菌の感染症治療薬の生産
知的財産データ
知財関連番号 : 特願2024-140864
発明者 : 伊藤 幸博、板垣 実菜子、藤田 岳、米山 裕、下田 蒼
技術キーワード: 抗菌ペプチド、Persulcatusin、牛乳房炎治療薬、タンパク質生産、ペプチド生産
